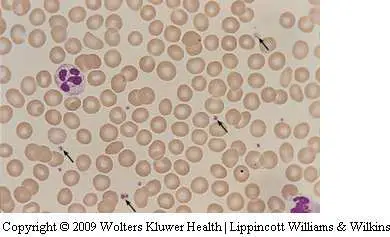
圖片

107年:(醫檢)血液(1)
觀察 Wright-Giemsa 染色的血液抹片,下圖箭頭所指為何?
A血小板
B未成熟紅血球
C細菌
D紅血球碎片
詳細解析
本題觀念:
本題考查 Wright-Giemsa 染色血液抹片中各種小型顆粒狀結構的形態辨識,特別是**血小板(platelets/thrombocytes)**在染色血液抹片中的外觀特徵,以及如何與紅血球碎片(schistocytes)、細菌及未成熟紅血球加以區分。
影像分析:
圖片為 Wright-Giemsa 染色的血液抹片(Copyright 2009 Wolters Kluwer Health / Lippincott Williams & Wilkins)。視野中可見大量正常型態的紅血球(euthrocytes),外形圓整、中央淡染(central pallor)明顯。圖中以多支箭頭指向分散於紅血球之間的數個微小結構,這些結構具有以下特徵:
- 體積極小(直徑約 1–3 μm,遠小於紅血球的 6–8 μm)
- 形態不規則,呈卵圓形或輕度不規則形
- 染色呈紫藍色至紫紅色,中央可見嗜酸性紫紅色顆粒(alpha granules)
- 無核,與有核的未成熟紅血球明顯不同
- 散布於紅血球之間的背景中
視野左側可見一個白血球(leukocyte)作為對比。箭頭所指的多個微小紫色顆粒,是典型的**血小板(platelets)**形態。
選項分析
(A) 血小板 ✅ Wright-Giemsa 染色下,血小板
...(解析預覽)...

升級 VIP 解鎖圖文解析